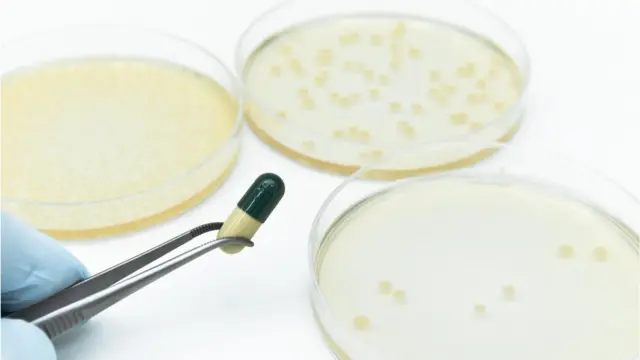
.

Résistance aux antibiotiques : elle pourrait causer des millions de décès chaque année selon l'OMS

Crédit photo, Daily Herald Archive
- Temps de lecture: 6 min
Le médecin et biologiste britannique Alexander Fleming, tout en recevant le prix Nobel pour sa découverte du premier antibiotique au monde, n'a pas oublié de mettre en garde contre la capacité généralisée des bactéries à se développer pour devenir résistantes aux antibiotiques.
Aujourd'hui, plus de 90 ans après sa découverte, la pénicilline, a révolutionné la médecine et les soins de santé modernes. L'Organisation mondiale de la santé a décrit les microbes résistants aux antibiotiques comme « le danger pour la santé le plus urgent de notre époque » ; Il menace de « renverser un siècle » d'avancées médicales mondiales.
" L'épidémie invisible ''
L'Organisation mondiale de la santé rapporte que la consommation mondiale d'antibiotiques a connu un énorme bond depuis le début du troisième millénaire. L'OMS surveille l'utilisation d'environ 34,8 milliards de doses d'antibiotiques chaque année, la consommation mondiale ayant augmenté de 65 % entre 2000 et 2015.
L'organisation considère que l'abus et la surutilisation des antimicrobiens sont les principaux moteurs de l'émergence de microbes résistants aux médicaments, que l'organisation mondiale a décrits comme une "épidémie invisible" qui pourrait être "plus meurtrière à long terme que le virus Corona". On s'attend à ce qu'elle cause environ 10 millions de décès par an.
Lire aussi sur BBC Afrique :
Le danger d'abuser de ces médicaments est qu'ils permettent aux bactéries et aux microbes de se développer pour devenir résistants aux antibiotiques. Environ 700 000 personnes meurent chaque année dans le monde, dont 300 000 nouveau-nés, en raison de l'inefficacité des médicaments anti-inflammatoires, et l'on s'attend à ce que les chiffres augmentent.
Et les rapports mondiaux sur le sujet indiquent qu'un antibiotique sur cinq est prescrit, en Grande-Bretagne, et qu'un antibiotique sur trois est prescrit aux États-Unis, sans besoin médical.

"Une erreur que je paie toujours"
L'histoire de l'Egyptienne Rasha Ismail a commencé avec les antibiotiques il y a plus de 15 ans, lorsqu'elle a subi une césarienne dans le Royaume d'Arabie saoudite ; « Le médecin supervisant l'opération a oublié de retirer une partie du placenta », ce qui l'a exposée à des infections, après quoi le médecin a prescrit plusieurs antibiotiques, sur une période de deux mois entiers.
Rasha s'est tournée vers un autre médecin et a subi une intervention chirurgicale pour retirer la partie coincée du placenta, mais les effets de son utilisation prolongée d'antibiotiques lui ont causé des ulcères à l'estomac et au côlon.
Elle dit que son traitement antibiotique a considérablement perturbé son microbiome intestinal. Les antibiotiques tuent les bactéries intestinales bénéfiques. "J'ai réussi à me remettre des ulcères d'estomac, mais je n'ai pas encore pu me remettre des ulcères du côlon, " poursuit-elle.
Rasha explique que le défaut qui afflige son système immunitaire en raison de l'utilisation excessive d'antibiotiques et de leur effet sur les microbes de l'estomac, a fait de son corps une cible facile pour une infection virale, et par conséquent, elle a contracté la maladie de la « ceinture de feu » des mois après avoir subi une césarienne.
Crédit photo, unoL
Coup d'État contre la révolution de la pénicilline
Les antimicrobiens, y compris les antibiotiques, les antiviraux, les antifongiques et les antiparasitaires, sont utilisés pour prévenir et traiter les infections chez les humains, les animaux et les plantes.
La résistance aux antimicrobiens se produit lorsque des bactéries, des virus, des champignons et des parasites modifient leurs propriétés au fil du temps, affaiblissant ou annulant complètement l'efficacité de ces médicaments. Ce qui augmente le risque de propagation des maladies et augmente leur taux de mortalité, ainsi que la durée des séjours à l'hôpital, et a ainsi coûté des millions de dollars à l'économie mondiale. Ce qui laisse présager un retour à l'ère de la découverte de la pénicilline, qui a fait une énorme révolution dans la médecine et les soins de santé modernes.
Ahmed Mostafa, spécialiste en médecine critique à la Faculté de médecine de l'Université égyptienne d'Alexandrie, déclare que le taux de résistance aux antibiotiques en Egypte se situe entre 70 et 90 pour cent, et que seulement 4 pour cent des antibiotiques prescrits en dehors des hôpitaux en Egypte ont été prescrits sur la base des résultats des tests de culture en laboratoire dit le docteur. .
Le Dr Ahmed ajoute qu'il a été témoin de nombreux décès dus à une infection par des microbes résistants aux antibiotiques (MDR), au cours de son travail dans les unités de soins intensifs de plusieurs hôpitaux égyptiens, mais la chose la plus dangereuse est que « ces dernières années, nous avons été témoins d'une augmentation des infections par des bactéries résistantes à tous les types d'antibiotiques PDR, qui sont des bactéries, parfois appelées « super bactéries. »

Plan de lutte mondial
En mai 2015, l'Organisation mondiale de la santé a lancé un plan mondial de lutte contre la résistance aux antimicrobiens, y compris la résistance aux antibiotiques. Il vise à accroître la sensibilisation au phénomène, à renforcer la recherche et la surveillance, à réduire les taux d'infection, à rationaliser l'utilisation des médicaments antimicrobiens et à garantir la durabilité investissement dans le domaine de la lutte contre la résistance aux antimicrobiens, par le développement de nouveaux médicaments plus efficaces.
Dans le cadre de ce plan, l'organisation a lancé la Semaine mondiale de sensibilisation aux antibiotiques, en novembre de la même année, dans le cadre d'une campagne de sept ans. Cependant, les défis qui menacent le succès de la campagne mondiale ne s'arrêtent pas à l'engagement des individus, des professionnels de la santé et des décideurs politiques dans les pays qui adoptent le plan de l'organisation aux règles fixées par ce dernier afin de retarder la survenue de la catastrophe scénario, qui verra le monde revenir à l'ère d'avant la découverte de la pénicilline, mais plutôt aller au-delà pour exhorter les cercles. L'industrie de la santé investit dans la recherche et le développement concernant les antibiotiques, les vaccins et les outils de diagnostic.
This article contains content provided by Google YouTube. We ask for your permission before anything is loaded, as they may be using cookies and other technologies. You may want to read the Google YouTube cookie policy and privacy policy before accepting. To view this content choose 'accept and continue'.
Fin de YouTube publication
« Nous devons saisir les opportunités découlant de l'épidémie de Covid-19 pour mettre en évidence les besoins d'investissements durables dans la recherche et le développement d'antibiotiques nouveaux et efficaces », a déclaré Heilisus Jethun, directeur de la coordination mondiale du Programme mondial de résistance aux antimicrobiens à l'OMS.
Mais ce qui est intéressant, c'est que le déclenchement de l'épidémie de Coronavirus a coïncidé avec une énorme augmentation de la demande d'achat d'antibiotiques ; surtout dans le monde arabe, où la sensibilisation médicale est absente et où il est facile d'obtenir ces médicaments sans peu de contrôle dans de nombreux pays.
Ce qui exacerbe la gravité de la situation, c'est ce que le dernier rapport publié par l'organisation, en avril dernier, indique que le monde n'a pas encore été en mesure de développer des traitements antibactériens urgents, malgré la prise de conscience croissante de la menace imminente de la résistance aux antibiotiques.
L'organisation révèle, dans son rapport, qu'un total des 43 antibiotiques actuellement en cours de développement clinique ne répondent pas de manière adéquate au problème de la résistance aux médicaments des bactéries les plus dangereuses au monde.

Crédit photo, KATERYNA KON/SCIENCE PHOTO LIBRARY
Qu'est-ce qui empêche le développement de nouveaux antibiotiques?
Selon le rapport de l'OMS, l'impact de la résistance aux antimicrobiens est plus grave dans les milieux défavorisés et parmi les groupes vulnérables tels que les nouveau-nés et les jeunes enfants.
La pneumonie bactérienne et les infections de la circulation sanguine des principales causes de mortalité infantile de moins de cinq ans, provoquant une infection bactérienne résistante à la plupart des antibiotiques primaires dans la mort de près de 30 pour cent des nouveau-nés infectés par une septicémie (ou septicémie - Sepsis ) . Malgré cela, l'OMS constate que les grandes sociétés pharmaceutiques sont réticentes à investir dans le développement d'antibiotiques. Un récent rapport de l'ONU a conclu que la recherche et le développement dans le domaine des antibiotiques sont menés par des petites ou moyennes entreprises.
Le pharmacien égyptien Moaz Lotfi en attribue les raisons au fait que « la bataille pour développer de nouveaux antibiotiques nécessite de mobiliser quotidiennement les efforts de milliers de chercheurs face à des millions de bactéries génétiquement mutées, compte tenu de la disponibilité des raisons qui coopèrent à ce sujet », ce qui signifie « dépenser des millions de dollars pour développer des « médicaments bon marché auxquels les bactéries pourront résister au fil du temps ».
Lutfi conclut son intervention en soulignant la nécessité d'efforts concertés pour réduire l'usage excessif de ces médicaments et durcir les restrictions à leur prescription par les médecins ou à leur délivrance par les pharmaciens, parallèlement aux efforts de recherche et développement concernant le développement d'antibiotiques plus efficaces.






















